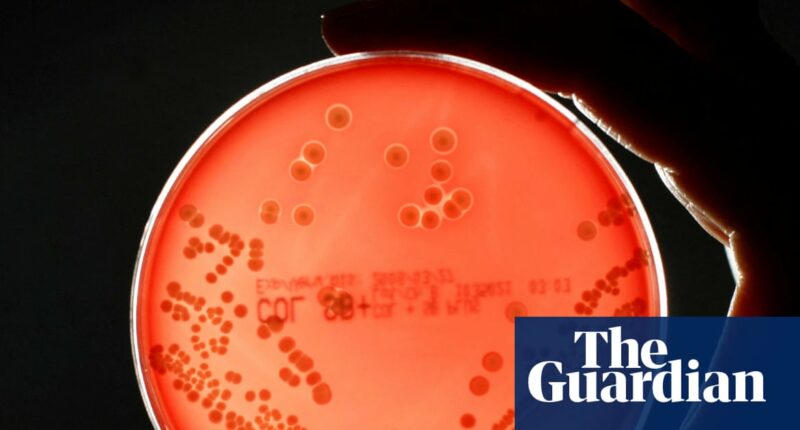
Pipeline of new drugs to fight superbugs is ‘worryingly thin’, experts warn

The development of new medications to combat drug-resistant superbugs has significantly declined, shrinking by 35% over the past five years, according to experts. They warn that the annual global death toll from these infections could surge to 8 million by 2050.
A recent report by the Access to Medicine Foundation (AMF), a non-profit organization based in the Netherlands and supported by the Wellcome Trust, reveals a concerning reduction in antimicrobial projects by major pharmaceutical companies. The number of drugs in the development pipeline has dropped from 92 to just 60, with only five targeted specifically for children under five, a particularly vulnerable group.
Jayasree K Iyer, the CEO of the foundation, expressed deep concern about the current state of research and development, describing it as “worryingly thin.” She emphasized that the stagnation in industry investment poses a significant threat to global healthcare, with drug resistance being the most critical challenge.
Currently, drug-resistant infections are directly responsible for over 1 million deaths annually, and they play a role in 4 million deaths worldwide each year. These numbers are projected to double by 2050, reaching nearly 2 million direct deaths and more than 8 million associated fatalities.
Ara Darzi, a renowned cancer surgeon and executive chair of the Fleming Initiative, which addresses antimicrobial resistance, highlighted the pharmaceutical industry’s “moral responsibility” in managing these risks. He pointed out that infections rank as the second leading cause of death among cancer patients.
At the launch of the AMF report, Lord Darzi remarked on the tragic irony that advancements in cancer treatments are often undermined by infections that were readily treatable just a decade ago. “You can’t win a game if you have three good strikers and your defense is weak,” he stated, underscoring the importance of a robust defense against infections.
The Fleming Initiative – named after the Scottish physician Alexander Fleming who discovered penicillin in London almost 100 years ago – is predicting up to 10 million deaths from drug-resistant infections by 2050.
The UK’s GSK is leading the way in antimicrobial research with 30 projects and is one of just three big pharma companies that continue to invest in this area, the report found.
The other two big players are Japan’s Shionogi and Otsuka, while the US drugmaker Pfizer, which was joint first with GSK in 2021, has fallen back.
Claudia Martínez, AMF’s director of research, said: “We don’t have enough research going into antimicrobials to outpace resistance.”
Britain’s biggest pharmaceutical company, AstraZeneca, is not included in the ranking because it does not have an antibiotic portfolio, as infectious diseases has never been its focus. The report assesses the efforts of 25 companies, including seven large research-based firms, 10 generic medicine manufacturers and eight smaller drug developers, or biotechs.
Iyer said three recently approved antibiotics and seven other promising medicines in late-stage development showed “it is possible to tilt the battle against superbugs in humanity’s favour”.
In December, the US health regulator approved the Californian biotech Innoviva’s oral antibiotic Nuzolvence to treat gonorrhea, as well as GSK’s Blujepa for uncomplicated urinary tract infections and urogenital gonorrhea. They are the first antibiotics developed to treat these diseases in decades.
People in low- and middle-income countries, where infectious diseases hit hardest, are most vulnerable to drug-resistant superbugs. “There is no time to lose,” Iyer said. Restricting overuse of antibiotics, including in food production, and managing antibiotic waste responsibly were also important.
Hospitals across the world have recorded an alarming rise in common infections that are resistant to antibiotics. One in six laboratory-confirmed bacterial infections were resistant to antibiotic treatments in 2023, with more than 40% of antibiotics losing potency against common blood, gut, urinary tract and sexually transmitted infections between 2018 and 2023, according to the World Health Organization.
John-Arne Røttingen, the chief executive of the Wellcome Trust, said the lack of effective antibiotics was a “big challenge for society”. As the market for new antibiotics is not lucrative for many pharma companies, the European Commission wants to introduce transferable exclusivity vouchers to grant antimicrobial drug developers an extra 12 months of data protection.
Røttingen also said the NHS’s subscription model for antibiotics, giving drugmakers a guaranteed revenue stream, should be adopted by other high-income countries.